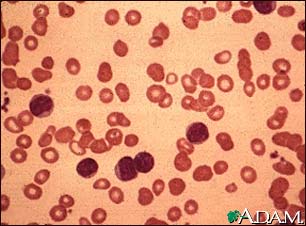
Chronic lymphocytic leukemia - microscopic view

![]() | ![]() | ![]() |
| | ||
Chronic lymphocytic leukemia - microscopic view
This is a microscopic view of bone marrow from a person with chronic lymphocytic leukemia; it shows predominantly small, mature lymphocytes.
Update Date: 7/11/2008 Updated by: David C. Dugdale, III, MD, Professor of Medicine, Division of General Medicine, Department of Medicine, University of Washington School of Medicine; and James R. Mason, MD, Oncologist, Director, Blood and Marrow Transplantation Program and Stem Cell Processing Lab, Scripps Clinic, Torrey Pines, California. Also reviewed by David Zieve, MD, MHA, Medical Director, A.D.A.M., Inc.
